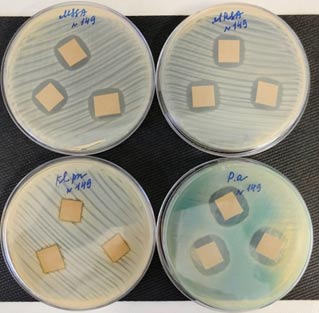

2025 год № 3
Медико-биологические науки
1emgordina@win.rniito.ru, https://orcid.org/0000-0003-2326-7413
2clinpharm-rniito@yandex.ru, https://orcid.org/0000-0002-2083-2424
4mailbox@dlabutin.com, https://orcid.org/0000-0002-4405-7688
3,5Радиотехкомплект, Санкт-Петербург, Россия
3chemical-man@yandex.ru, https://orcid.org/0000-0003-2327-2466
5mvbogma@gmail.com, https://orcid.org/0009-0002-8446-5114
Аннотация:
Ключевые слова:
1emgordina@win.rniito.ru, https://orcid.org/0000-0003-2326-7413
2clinpharm-rniito@yandex.ru, https://orcid.org/0000-0002-2083-2424
4mailbox@dlabutin.com, https://orcid.org/0000-0002-4405-7688
3,5Rtkt, St. Petersburg, Russian Federation
3chemical-man@yandex.ru, https://orcid.org/0000-0003-2327-2466
5mvbogma@gmail.com, https://orcid.org/0009-0002-8446-5114
Abstract:
Key words:
Введение |
 |
 |
Ортопедические имплантаты (устройства для фиксации переломов, искусственные протезы, заменяющие суставы и межпозвоночные диски, и наполнители костных дефектов) помогают восстанавливать и поддерживать структуру и функцию поврежденного опорно-двигательного аппарата [1]. Имплантат-ассоциированная инфекция является одним из наиболее тяжелых осложнений, развивающихся в 1-2 % случаях после первичного и в 4 % - ревизионного эндопротезирования сустава [2]. Помимо заболеваемости и смертности, имплантат-ассоциированные инфекции (ИАИ) наносят значительный экономический ущерб системе здравоохранения и обществу. Так, по данным Premkumar в США средняя стоимость лечения ИАИ бедра или колена составляет около 100 тыс. долларов на человека, а к 2030 году экономическое бремя ППИ, связанное с тазобедренным и коленным суставами, может достичь 1,85 млрд долларов [1]. Кроме того, весьма актуальным является развитие инфекции области хирургического вмешательства (ИОХВ), которая встречается примерно в 1 % случаев после хирургических вмешательств [3].
Наиболее значимыми возбудителями инфекционных заболеваний с часто регистрируемой множественной лекарственной устойчивостью являются Staphylococcus aureus, Klebsiella pneumoniae, Escherichia coli, Acinetobacter baumannii и Pseudomonas aeruginosa. Представители данных видов бактерий в 2019 году стали причиной более 330 000 смертей, связанных с устойчивостью к антибиотикам [4] и входят в список приоритетных этиопатогенов ВОЗ 2024 года [5]. По данным 12-летнего ретроспективного исследования ведущими возбудителями в травматологии и ортопедии среди грамположительных бактерий являются S. aureus (31,3 %), грамотрицательных - P. aeruginosa (4,8 %) и K. pneumoniae (3,9 %) [6]. Данные возбудители характеризуются наличием различных факторов вирулентности, способны образовывать биопленки, а также интернализировать остеобласты и остеоциты, поэтому ключевым моментом является предупреждение формирования зрелой биопленки на имплантате и, как следствие, персистирующего микробного очага.
В качестве периоперационной антибиотикопрофилактики при первичном эндопротезировании назначают антибактериальные препараты. Однако наличие у патогена устойчивости к антибиотикам приводит к снижению или полной неэффективности препаратов и как следствие к увеличению сроков госпитализации, повышению экономических затрат на лечение хронической рецидивирующей ортопедической инфекции и реабилитацию пациентов [7].
Одним из перспективных направлений борьбы с хроническим течением перипротезных инфекций, связанных с образованием микробных биопленок возбудителями, является применение различных частиц металлов и их соединений для обеспечения антимикробных свойств материалам, в том числе имплантатам. В настоящее время опубликованы многочисленные научные исследования, показывающие, что наночастицы металлов демонстрируют высокий антимикробный потенциал и могут быть альтернативой антибактериальным препаратам, особенно при местном применении. Среди них серебро и цинк являются одними из наиболее часто применяемых металлов и их соединений в медицине [8, 9]. Резистентность среди возбудителей инфекционной патологии к наночастицам металлов регистрируют крайне редко, что можно объяснить значительным количеством мишеней воздействия на поверхности и внутри бактериальной клетки [10]. Многонаправленность действия частиц металлов и их соединений обеспечивает значительное количество направлений и возможностей применения комплексных покрытий различных носителей с приданием им антибактериальных свойств.
Цель исследования - оценка антибактериального действия комплексов оксидов титана, цинка, магния и серебра, нанесенных на различные носители, их цитосовместимость и сохранение активности после стерилизации.
Материалы и методы
|
 |
 |
Получение покрытий с серебром и его оксидами. Комплексные покрытия с частицами оксидов магния, титана, цинка, серебра осаждались на носитель в вакууме методом дугового ионно-плазменного распыления металлической мишени, мощность разряда - 1500 Вт, при варьировании рабочего давления в течение 3 минут реакционного газа кислорода Р=(0,2-2)ä10-3 мм рт. ст. Толщину покрытия определяли весовым методом по стеклянному образцу-свидетелю на аналитических весах - 120-150 нм. Испытание адгезии пленок комплексов оксидов для стеклянного образца-свидетеля проводили методом решетчатого надреза. Получены комплексы оксидов металлов трех видов - TiO2-AgO-TiO2, ZnO-AgO-ZnO, MgO-AgO-MgO и нанесены на перевязочный материал, изготовленный по технологии Спанлейс (40 г/м), сферы из медицинской стали (d=5мм), 3d-образцы медицинского титана (5 мм3), кубы из медицинского титана (10 мм3), углерод-углеродный композиционный материал (УУКМ, 5 мм3).

Рис. 1. Пример готовых образцов различных носителей с комплексом ZnO-AgO-ZnO
Примечание. 1 - УУКМ; 2 - 3D-образцы медицинского титана; 3 - перевязочный материал; 4 - кубы из медицинского титана; 5 - сферы из медицинской стали.
Микрофотографии образцов с покрытием фиксировали на сканирующем электронном микроскопе (СЭМ) MINI SEM A5100 (КНР). Кроме того, для исследования поверхности микропробы полученных образцов ткани зафиксированные на держатель помещали в камеру СЭМ ТМ 4000 Plus (Hitachi), имеющую спектрометр энергетической дисперсии XFlash 610 Mini. Разрешение спектрометра 143 эВ, точность измерения 0,01-1 %. Для определения состава покрытий выполняли элементный анализ при ускоряющем напряжение 15 кэВ, рабочее расстояние - 10 мм, зондовый ток - 1,4 нА, глубина зондирования - 0,5-1 микрона, угол отбора характеристического рентгеновского излучения - 25 градусов. Детекцию осуществляли по всей поверхности образца в нескольких точках путем оценки испускаемого рентгеновского излучения.
Определение антимикробной активности. Для выявления наличия и длительности антибактериальной активности оксидных комплексов на поверхности различных носителей выполняли скрининг всех тестируемых комплексов покрытий в отношении Staphylococcus aureus АТСС 29213 (MSSA). Образцы погружали в 3 мл бульона Мюллера-Хинтона (МХБ), содержащего 1ä10ä6 КОЕ/мл бактерий. В качестве контроля в МХБ вносили образцы без покрытий. Пробирки инкубировали 24 часа при температуре 37 °С. При наличии статистически значимой разницы между значениями оптической плотности (ОП) инкубационных сред с тестируемыми образцами и контролем (инкубационные среды с образцами без покрытия) покрытия считали активными. При наличии мутности в пробирках для исключения контаминации выполняли посев бульонных культур с последующей идентификацией. Без признаков роста бактерий, питательную среду удаляли и заменяли на 3 мл МХБ с 1ä10ä6 КОЕ/мл бактерий, процедуру повторяли ежедневно до появления признаков роста в опытных пробирках.
Аналогично выполнена оценка возможных изменений антибактериальной активности образцов с комплексом ZnO-AgO-ZnO после низкотемпературной плазменной стерилизации в STERRAD в отношении S. aureus АТСС 29213 (MSSA) и P. aeruginosa ATCC 27853.
Антибактериальную активность образцов нетканого медицинского материала, изготовленного по технологии Спанлейс (40 г/м2) с наиболее активным комплексом ZnO-AgO-ZnO изучали диффузионным методом в отношении эталонных штаммов бактерий. Грамположительные: метициллин-чувствительный S. aureus АТСС 29213 (MSSA), метициллин-устойчивый S. aureus ATCC 43300 (MRSA); грамотрицательные: K. pneumoniae ATCC 33495, P. aeruginosa ATCC 27853. Образцы (1 см2) помещали на бактериальный газон на агаре Мюллера-Хинтона и убирали в термостат (37 °С). Через 24 часа выполняли визуальную оценку антибактериальных свойств образцов по наличию зоны подавления роста бактерий.
Определение цитотоксичности. Эукариотические клетки Vero выращивали в модифицированной среде Dulbecco MEM/F12 с высоким содержанием глюкозы, L-глутамина, пирувата натрия (Corning, США), эмбриональной бычьей сыворотки (10 %) (HiMedia, Индия), пенициллина 100 ед./мл и стрептомицина 100 мг/мл (Capricorn, Германия). Каждые 3-4 дня клетки разделяли в соотношении 1:3. Материал (1 см2) помещали на сутки в 3 мл культуральной среды в шейкер (+37 °С, 150 об./мин.), а экстракты хранили при +4 °С. Через 24 часа в лунки (2 000 клеток Vero) вносили 200 мкл полученного экстракта. Образцы углеродного носителя объемом 1 см3 засевали суспензией клеток Vero в количестве 50 000/куб. в 24-луночных полистироловых планшетах. Через 72 ч инкубации в лунки вносили раствор 3-(4,5-диметилтиазол-2ил)-2,5-дифенилтетразолия бромида (МТТ) в итоговой концентрации 1 мг/мл и инкубировали еще 3 ч. Раствор в лунках заменяли на 1 мл ДМСО и инкубировали в шейкере (200 об./мин., 5 мин.). 100 мкл полученного раствора переносили в лунку 96-луночночного планшета, измеряли ОП на спектрофотометре INNO-S. Определяли разницу ОП при длине волн 570 нм и 620 нм с вычитанием сигнала пустых лунок и образцов без клеток в случае углеродного носителя. Жизнеспособность Vero определяли как долю ОП570-620 в исследуемых образцах относительно ОП570-620 в контрольных лунках.
Статистический анализ. Результаты проанализированы методом t-теста с корректировкой Уэлча в программе GraphPad Prism 9.0. Значения p < 0,05 считали статистически значимыми.
Результаты и обсуждение
|
 |
 |
Протестированные носители разработанных покрытий с комплексами оксидов металлов TiO2-AgO-TiO2, ZnO-AgO-ZnO, MgO-AgO-MgO демонстрировали наличие антибактериальных свойств различной длительности (табл. 1), за исключением сфер из медицинской стали, что, по-видимому, может быть связано с малой площадью поверхности и недостаточным количеством покрытия для ингибирования роста бактерий.
| Носитель/подложка | TiO2-AgO-TiO2 | ZnO-AgO-ZnO | MgO-AgO-MgO |
|---|---|---|---|
| Перевязочный материал | 1 | 3 | 8 |
| Медицинский титан | 1 | 1 | 1 |
| Медицинская сталь (сферы) | 0 | 0 | 0 |
| Медицинский титан (кубы) | 1 | 2 | 1 |
| УУКМ | 3 | 3 | 1 |
Показано, что на поверхности перевязочного материала наиболее длительный антибактериальный эффект демонстрировал комплекс MgO-AgO-MgO, однако на других носителях для этого состава регистрировали минимальную антибактериальную активность. В свою очередь комплекс ZnO-AgO-ZnO на кубах из медицинского титана и УУКМ ингибировал рост S. aureus АТСС 29213 более продолжительное время, поэтому в дальнейшем более детально изучен данный состав разработанного покрытия.
Элементный анализ поверхности нетканого медицинского материала показал наличие серебра - 31,5 %, кислорода - 17,24 %, цинка - 48,9 % и отсутствие примесей других элементов.
Микрофотографии подтверждают равномерное распределение комплекса ZnO-AgO-ZnO на поверхности носителя (рис. 2).

Рис. 2. А - Оптическая микрофотография образца ткани с ZnO-AgO-ZnO, Magä400. Б - СЭМ поверхности образцов
Установлено, что комплекс ZnO-AgO-ZnO, нанесенный на нетканый медицинский материал демонстрировал антибактериальное действие в отношении эталонных штаммов грамположительных и грамотрицательных бактерий (рис. 3).
Рис. 3. Зоны подавления роста эталонных штаммов бактерий вокруг образцов нетканого медицинского материала с комплексом ZnO-AgO-ZnO. MSSA - метициллин-чувствительный S. aureus 29213; MRSA - метициллин-резистентный S. aureus 43300; Pa - P. aeruginosa 27853; Kp - K. pneumoniae 33495
Установлено, что антибактериальная активность полученного многослойного комплекса ZnO-AgO-ZnO не снижалась после низкотемпературной плазменной стерилизации (табл. 2).
| Штамм | Носитель | Длительность активности | |
|---|---|---|---|
| до стерилизации | после стерилизации | ||
| S. aureus 29213 | Спанлейс | 3 | 3 |
| P. aeruginosa 27853 | Спанлейс | 4 | 4 |
Исследование цитосовместимости носителей с комплексом ZnO-AgO-ZnO показало, что через 72 ч инкубации количество жизнеспособных эукариотических клеток с образцами нетканого материала без комплекса относительно контроля было снижено (рис. 4, 5). Доля клеток в лунках при наличии комплекса с оксидами цинка и серебра была значимо ниже, чем в образцах ткани без комплекса (p=0,01) (рис. 4А), практически до полного отсутствия жизнеспособных клеток. Аналогичные результаты получены и при исследовании цитотоксичности ZnO-AgO-ZnO на УУКМ. Доля жизнеспособных клеток в присутствии образцов с ZnO-AgO-ZnO была значимо меньше, чем с нативными образцами УУКМ (p=0,02) (рис. 4Б).

Рис. 4. Жизнеспособность клеток Vero после инкубации в течение 72 часов: А - с экстрактами образцов нетканого материала, Б - на поверхности углеродного носителя

Рис. 5. Отложение формазана в клетках на поверхности пластика (темные участки) в присутствии исследуемых образцов, после реакции жизнеспособных клеток Vero с MTT в течение 3 часов (10X)
В травматологии и ортопедии более чем в 40 % случаях инфекционных заболеваний, в частности связанных с различными имплантатами, возбудителем являются S. aureus, P. aeruginosa, K. pneumoniae, которые характеризуются значительным набором различных механизмов устойчивости к антибактериальным препаратам и антисептикам [6]. Кроме того, формирование микробных биопленок на имплантате, особенно образованных несколькими видами бактерий, приводит к длительному существованию патогена в организме, а также обеспечивает защиту от факторов иммунной системы и от антибактериальных препаратов, что в свою очередь приводит к хронизации инфекционного процесса и затяжному течению болезни.
По данным научной литературы устойчивость к наночастицам металлов является крайне редким явлением, поэтому значительный интерес представляют данные о возможности их применения для модификации поверхностей перевязочного материала или имплантатов из стали или титана за счет нанесения активного покрытия с частицами металлов и придание им антиадгезивных и антибактериальных свойств.
В нашем исследовании образцы покрытые комплексами оксидов металлов, характеризовались наличием выраженных антибактериальных свойств в отношении S. aureus. Однако образцы сферической формы, не оказывали антибактериального действия. В исследовании Ning с соавторами было установлено, что минимальная ингибирующая концентрация (МИК) частиц серебра и частиц цинка в среде против S. aureus составляет 10-7 моль/л, поэтому можно предположить, что при исследовании антибактериальной активности сферических образцов итоговая концентрация частиц серебра была ниже МИК [11].
Благодаря своей хорошей биосовместимости и коррозионной стойкости, высокой прочности титан широко используется в ортопедических материалах, включая протезы и пластины для фиксации переломов, гвозди, стержни, винты, проволоку. В выполненном нами исследовании протестированы покрытия, обеспечивающие образцам из медицинского титана антибактериальные свойства, при этом комплекс ZnO-AgO-ZnO показал наилучшие результаты, чем комплексы TiO2-AgO-TiO2 и MgO-AgO-MgO. Многокомпонентное покрытие ZnO-AgO-ZnO также демонстрировало выраженную антибактериальную активность и на поверхности перевязочного материала в отношении эталонных штаммов грамположительных и грамотрицательных бактерий, включая метициллин-резистентный штамм S. aureus. Наибольшую активность данного комплекса регистрировали в отношении P. aeruginosa, наименьшую против K. pneumoniae. Следует отметить, что процесс низкотемпературной плазменной стерилизации образцов нетканого материала не снижал антибактериальные свойства разрабатываемых покрытий.
Максимальную длительность активности против S. aureus многокомпонентных покрытий на нетканом медицинском материале определяли у комплекса MgO-AgO-MgO (8 суток). В эксперементальной работе Wetteland CL с соавторами было установлено, что соединения магния характеризуются антибактериальным эффектом в отношении против E. coli и S. epidermidis, ускоряют пролиферацию мезенхимальных стволовых клеток (в концентрации 200 мг/л), а также подавляют бактериальную адгезию [12]. Придание антибактериальных свойств перевязочному материалу, сохраняющихся в течение нескольких дней, обеспечит более успешную и быструю элиминацию возбудителя раневой инфекции.
Несмотря на установленную высокую антибактериальную активность полученных многокомпонентных покрытий, в ряде научных работ была показана возможность формирования резистентности бактерий в различным наночастицам металлов [13, 14, 15]. В работе Panacek с соавторами показано, что E. coli и P. aeruginosa способны сверхэкспрессировать флагеллиновый матрикс, который вызывает агломерацию наночастиц серебра и предотвращает их прямой контакт с бактериями [13]. Faghihzadeh с соавторами описали адаптацию E. coli посредством синтеза внеклеточных веществ, изменяющих размер и потенциал наночастиц, вызывая их агломерацию [14].
Активные компоненты покрытий непосредственно контактируют с бактериями, разрушают внешнюю бактериальную мембрану и тем самым предотвращают адгезию бактерий и образование биопленки. Кроме того, среда вокруг перевязочного материала или имплантата претерпевает изменение pH. Показано, что при распаде покрытий и сплавов, содержащих магний, формируется щелочная среда, препятствующая росту бактерий. В свою очередь, разность потенциалов между компонентами покрытий вызывает перенос электронов, потребляет ионы водорода, влияет на активность протонного насоса и высвобождает большое количество свободных радикалов, что приводит к гибели патогена [16]. По-видимому, представленные механизмы действия оказывают влияние не только на бактериальные, но и на эукариотические клетки, что отражено в нашем исследовании в высокой цитотоксичности наиболее активного комплекса ZnO-AgO-ZnO в отношении культуры клеток Vero. В дальнейших исследованиях необходимо модернизировать технологию нанесения активного покрытия с сохранением антибактериальной активности, но при этом обеспечить большую цитосовместимость действующих веществ.
Вывод
|
 |
 |
Протестированы активные антибактериальные многокомпонентные покрытия, содержащие в своем составе оксиды различных металлов - TiO2-AgO-TiO2, ZnO-AgO-ZnO, MgO-AgO-MgO. Комплекс ZnO-AgO-ZnO, нанесенный на нетканый медицинский материал демонстрировал активность как в отношении грамположительных, так и в отношении грамотрицательных бактерий, а комплекс MgO-AgO-MgO подавлял рост S. aureus более недели. Равномерное распределение наночастиц соединений металлов по поверхности носителя, а также сохранение антибактериальной активности образцов после стерилизации, делают перспективным дальнейшие исследования разрабатываемых покрытий. Установленная на культуре эукариотических клеток цитотоксичность полученных комплексов требует дальнейшей оптимизации параметров получения покрытий для сохранения их антимикробной активности и снижения цитотоксичности в отношении клеток организма.
Список источников |
 |
 1. Premkumar A., Kolin D.A., Farley K.X., Wilson J.M., McLawhorn A.S., Cross M.B., Sculco P.K. Projected Economic Burden of Periprosthetic Joint Infection of the Hip and Knee in the United States // J Arthroplasty. - 2021. - № 36 (5). - Р. 1484-1489.e3. doi: 10.1016/j.arth.2020.12.005.
1. Premkumar A., Kolin D.A., Farley K.X., Wilson J.M., McLawhorn A.S., Cross M.B., Sculco P.K. Projected Economic Burden of Periprosthetic Joint Infection of the Hip and Knee in the United States // J Arthroplasty. - 2021. - № 36 (5). - Р. 1484-1489.e3. doi: 10.1016/j.arth.2020.12.005. 2. Vrancianu C.O., Serban B., Gheorghe-Barbu I., Czobor Barbu I., Cristian R.E., Chifiriuc M.C., Cirstoiu C. The Challenge of Periprosthetic Joint Infection Diagnosis: From Current Methods to Emerging Biomarkers // Int J Mol Sci. - 2023. - № 24 (5). - Р. 4320. doi: 10.3390/ijms24054320.
2. Vrancianu C.O., Serban B., Gheorghe-Barbu I., Czobor Barbu I., Cristian R.E., Chifiriuc M.C., Cirstoiu C. The Challenge of Periprosthetic Joint Infection Diagnosis: From Current Methods to Emerging Biomarkers // Int J Mol Sci. - 2023. - № 24 (5). - Р. 4320. doi: 10.3390/ijms24054320. 3. Dumville J.C., Gray T.A., Walter C.J., Sharp C.A., Page T., Macefield R., Blencowe N., Milne T.K., Reeves B.C., Blazeby J. Dressings for the prevention of surgical site infection // Cochrane Database Syst Rev. - 2016. - № 12 (12). - CD003091. doi: 10.1002/14651858.CD003091.
3. Dumville J.C., Gray T.A., Walter C.J., Sharp C.A., Page T., Macefield R., Blencowe N., Milne T.K., Reeves B.C., Blazeby J. Dressings for the prevention of surgical site infection // Cochrane Database Syst Rev. - 2016. - № 12 (12). - CD003091. doi: 10.1002/14651858.CD003091. 4. Antimicrobial Resistance Collaborators. Global burden of bacterial antimicrobial resistance in 2019: a systematic analysis // Lancet. - 2022. - № 399 (10325). - Р. 629-655. doi: 10.1016/S0140-6736(21)02724-0.
4. Antimicrobial Resistance Collaborators. Global burden of bacterial antimicrobial resistance in 2019: a systematic analysis // Lancet. - 2022. - № 399 (10325). - Р. 629-655. doi: 10.1016/S0140-6736(21)02724-0.  5. Ho C.S., Wong C.T.H, Aung T.T., Lakshminarayanan R., Mehta J.S., Rauz S., McNally A., Kintses B., Peacock S.J., de la Fuente-Nunez C., Hancock R.E.W., Ting D.S.J. Antimicrobial resistance: a concise update // Lancet Microbe. - 2024. - 100947. doi: 10.1016/j.lanmic.2024.07.010.
5. Ho C.S., Wong C.T.H, Aung T.T., Lakshminarayanan R., Mehta J.S., Rauz S., McNally A., Kintses B., Peacock S.J., de la Fuente-Nunez C., Hancock R.E.W., Ting D.S.J. Antimicrobial resistance: a concise update // Lancet Microbe. - 2024. - 100947. doi: 10.1016/j.lanmic.2024.07.010. 6. Касимова А.Р., Туфанова О.С., Гордина Е.М., Гвоздецкий А.Н., Радаева К.С., Рукина А.Н., Божкова С.А., Тихилов Р.М. Двенадцатилетняя динамика спектра ведущих возбудителей ортопедической инфекции: ретроспективное исследование // Травматология и ортопедия России. - 2024. - № 30 (1). - Р. 66-75. doi: 10.17816/2311-2905-16720.
6. Касимова А.Р., Туфанова О.С., Гордина Е.М., Гвоздецкий А.Н., Радаева К.С., Рукина А.Н., Божкова С.А., Тихилов Р.М. Двенадцатилетняя динамика спектра ведущих возбудителей ортопедической инфекции: ретроспективное исследование // Травматология и ортопедия России. - 2024. - № 30 (1). - Р. 66-75. doi: 10.17816/2311-2905-16720.  7. Laborda P., Gil-Gil T., Martínez J.L., Hernando-Amado S. Preserving the efficacy of antibiotics to tackle antibiotic resistance // Microb Biotechnol. - 2024. - № 17 (7). - e14528. doi: 10.1111/1751-7915.14528.
7. Laborda P., Gil-Gil T., Martínez J.L., Hernando-Amado S. Preserving the efficacy of antibiotics to tackle antibiotic resistance // Microb Biotechnol. - 2024. - № 17 (7). - e14528. doi: 10.1111/1751-7915.14528. 8. Talapko J., Matijević T., JuzbaŠić M., Antolović-Požgain A., Škrlec I. Antibacterial Activity of Silver and Its Application in Dentistry, Cardiology and Dermatology // Microorganisms. - 2020. - № 8 (9). - 1400. doi: 10.3390/microorganisms8091400.
8. Talapko J., Matijević T., JuzbaŠić M., Antolović-Požgain A., Škrlec I. Antibacterial Activity of Silver and Its Application in Dentistry, Cardiology and Dermatology // Microorganisms. - 2020. - № 8 (9). - 1400. doi: 10.3390/microorganisms8091400. 9. Божкова С.А., Гордина Е.М., Марков М.А., Афанасьев А.В., Артюх В.А., Малафеев К.В., Иванькова Е.М. Влияние комбинации ванкомицина с препаратом серебра на длительность антимикробной активности костного цемента и формирование биопленки штаммом MRSA // Травматология и ортопедия России. - 2021. - № 27 (2). - Р. 54-64. doi: 10.21823/2311-2905-2021-27-2-54-64.
9. Божкова С.А., Гордина Е.М., Марков М.А., Афанасьев А.В., Артюх В.А., Малафеев К.В., Иванькова Е.М. Влияние комбинации ванкомицина с препаратом серебра на длительность антимикробной активности костного цемента и формирование биопленки штаммом MRSA // Травматология и ортопедия России. - 2021. - № 27 (2). - Р. 54-64. doi: 10.21823/2311-2905-2021-27-2-54-64.  10. Gammoh N.Z., Rink L. Zinc in Infection and Inflammation // Nutrients. - 2017. - № 9 (6). - Р. 624. doi: 10.3390/nu9060624.
10. Gammoh N.Z., Rink L. Zinc in Infection and Inflammation // Nutrients. - 2017. - № 9 (6). - Р. 624. doi: 10.3390/nu9060624. 11. Ning C., Wang X., Li L., Zhu Y., Li M., Yu P., Zhou L., Zhou Z., Chen J., Tan G., Zhang Y., Wang Y., Mao C. Concentration ranges of antibacterial cations for showing the highest antibacterial efficacy but the least cytotoxicity against mammalian cells: implications for a new antibacterial mechanism // Chem Res Toxicol. - 2015. - № 28 (9). - Р. 1815-1822. doi: 10.1021/acs.chemrestox.5b00258.
11. Ning C., Wang X., Li L., Zhu Y., Li M., Yu P., Zhou L., Zhou Z., Chen J., Tan G., Zhang Y., Wang Y., Mao C. Concentration ranges of antibacterial cations for showing the highest antibacterial efficacy but the least cytotoxicity against mammalian cells: implications for a new antibacterial mechanism // Chem Res Toxicol. - 2015. - № 28 (9). - Р. 1815-1822. doi: 10.1021/acs.chemrestox.5b00258. 12. Wetteland C.L., Nguyen N.T., Liu H. Concentration-dependent behaviors of bone marrow derived mesenchymal stem cells and infectious bacteria toward magnesium oxide nanoparticles // Acta Biomater. - 2016. - № 35. - Р. 341-356. doi: 10.1016/j.actbio.2016.02.032.
12. Wetteland C.L., Nguyen N.T., Liu H. Concentration-dependent behaviors of bone marrow derived mesenchymal stem cells and infectious bacteria toward magnesium oxide nanoparticles // Acta Biomater. - 2016. - № 35. - Р. 341-356. doi: 10.1016/j.actbio.2016.02.032. 13. Panáček A., Kvítek L., Smékalová M., Večeřová R., Kolář M., RÖderová M., Dyčka F., Šebela M., Prucek R., Tomanec O. Bacterial resistance to silver nanoparticles and how to overcome it // Nat. Nanotechnol. - 2018. - № 13. - Р. 65. doi: 10.1038/s41565-017-0013-y.
13. Panáček A., Kvítek L., Smékalová M., Večeřová R., Kolář M., RÖderová M., Dyčka F., Šebela M., Prucek R., Tomanec O. Bacterial resistance to silver nanoparticles and how to overcome it // Nat. Nanotechnol. - 2018. - № 13. - Р. 65. doi: 10.1038/s41565-017-0013-y. 14. Faghihzadeh F., Anaya N., Astudillo-Castro C., Oyanedel-Craver V. Kinetic, metabolic and macromolecular response of bacteria to chronic nanoparticle exposure in continuous culture // Environ. Sci. Nano. - 2018. - э5:1386-1396. doi: 10.1039/C8EN00325D.
14. Faghihzadeh F., Anaya N., Astudillo-Castro C., Oyanedel-Craver V. Kinetic, metabolic and macromolecular response of bacteria to chronic nanoparticle exposure in continuous culture // Environ. Sci. Nano. - 2018. - э5:1386-1396. doi: 10.1039/C8EN00325D. 15. Niño-Martínez N., Salas Orozco M.F., Martínez-Castañón G.A., Torres Méndez F., Ruiz F. Molecular Mechanisms of Bacterial Resistance to Metal and Metal Oxide Nanoparticles // Int J Mol Sci. - 2019. - № 20 (11). - Р. 2808. doi: 10.3390/ijms20112808.
15. Niño-Martínez N., Salas Orozco M.F., Martínez-Castañón G.A., Torres Méndez F., Ruiz F. Molecular Mechanisms of Bacterial Resistance to Metal and Metal Oxide Nanoparticles // Int J Mol Sci. - 2019. - № 20 (11). - Р. 2808. doi: 10.3390/ijms20112808. 16. Jiao J., Zhang S., Qu X., Yue B. Recent Advances in Research on Antibacterial Metals and Alloys as Implant Materials // Front Cell Infect Microbiol. - 2021. - № 11. - 693939. doi: 10.3389/fcimb.2021.693939.
16. Jiao J., Zhang S., Qu X., Yue B. Recent Advances in Research on Antibacterial Metals and Alloys as Implant Materials // Front Cell Infect Microbiol. - 2021. - № 11. - 693939. doi: 10.3389/fcimb.2021.693939.
Телефон: (4212) 76-13-96
«Дальневосточный медицинский журнал»

